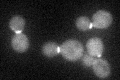
YBL105C
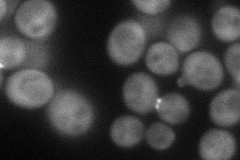
YBL105C
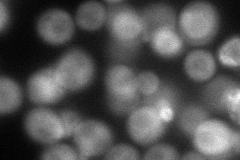
YBL105C
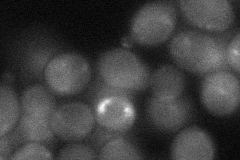
YBL105C

View description
Protein serine/threonine kinase essential for cell wall remodeling during growth; localized to sites of polarized growth and the mother-daughter bud neck; homolog of the alpha, beta, and gamma isoforms of mammalian protein kinase C (PKC)
Localization:
Intensity:
Fold change:
Significance:
-
C’ GFP library in SD
bud neckN/A -
N' NOP1pr-GFP in SD
bud neck69.9779 -
N' TEF2pr-mCherry in SD
cytosol,bud neck79.7159 -
N' NATIVEpr-GFP in SD

bud neck29.4605 -
N' TEF2pr-VC and Cyto-VN in SD
cytosol,bud neck40.2627 -
C’ GFP library in SD+DTT

bud neck35.710.99No -
C’ GFP library in SD+H2O2

bud neck35.970.99No -
C’ GFP library in Starvation Media

bud neck31.650.87No -
C’ GFP library on the background of Pup2-DaMP

N/A -
C’ GFP library on the background of CCT mutant

N/A0N/AYes
